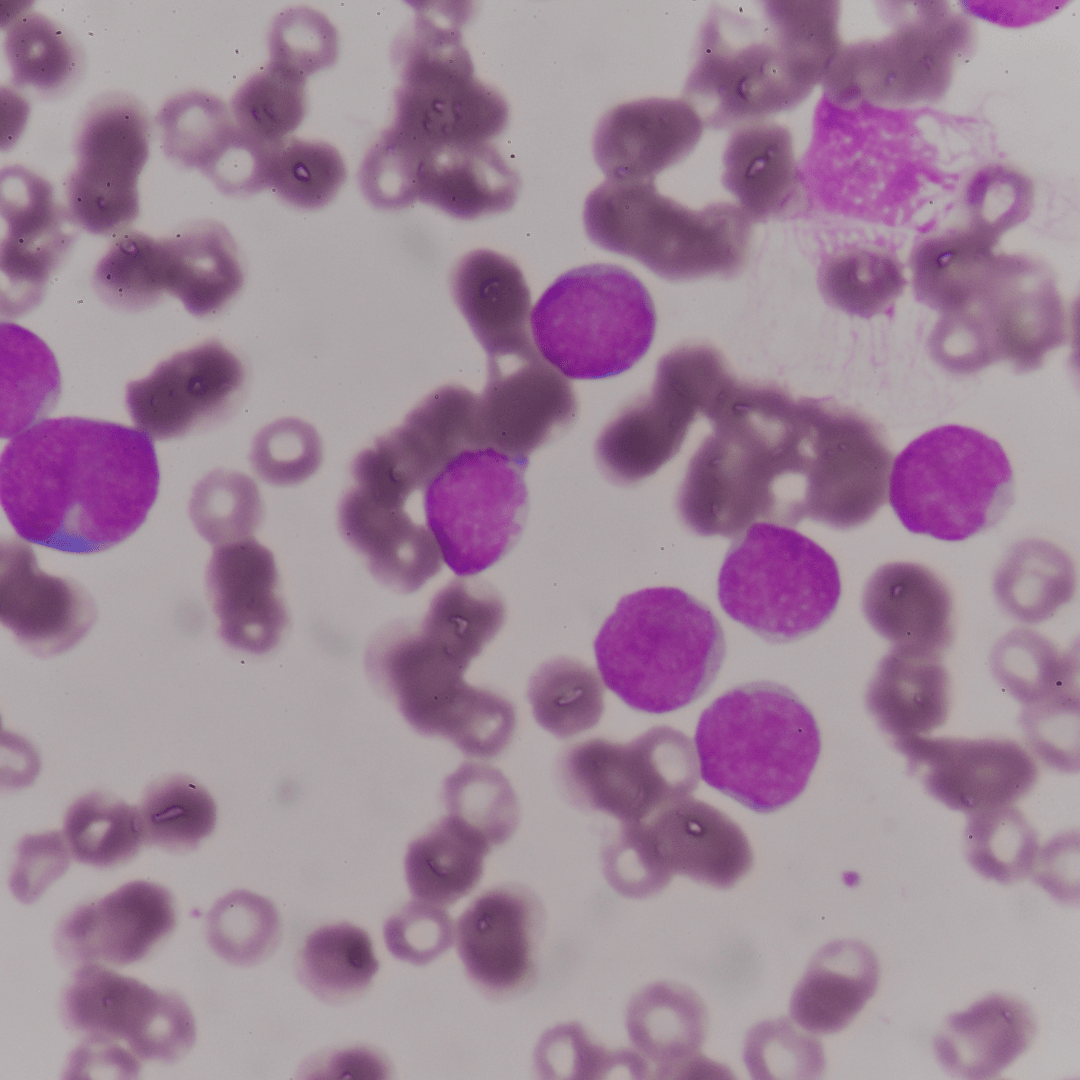

Que sont les exosomes?
Les exosomes sont de petites vésicules que nos cellules produisent elles-mêmes et utilisent pour communiquer entre elles. Ils contiennent des éléments précieux tels que des peptides, des facteurs de croissance, des lipides et du matériel génétique. On peut les comparer à des messages WhatsApp entre les cellules : ils envoient des instructions ciblées comme "produire du collagène" ou "réparer la barrière cutanée". Grâce à ces signaux, la peau peut se réparer et se régénérer.
Un exemple parlant : lorsque l’on coupe une branche d’un arbre, plusieurs nouvelles branches apparaissent souvent à cet endroit. Cela se produit parce que les cellules reçoivent un signal de réparation renforcée. Les exosomes font exactement la même chose dans notre peau : ils activent et stimulent les cellules pour qu’elles se régénèrent plus efficacement et plus solidement.
Peptides versus exosomes
Beaucoup de personnes confondent les peptides avec les exosomes, car tous deux communiquent avec les cellules. Pourtant, il existe une différence importante:
- Les peptides
sont de courtes chaînes d’acides aminés qui donnent une seule instruction, par exemple : « produire du collagène ».
- Les exosomes
sont de véritables paquets de communication qui transmettent plusieurs signaux en même temps. En plus des peptides, ils contiennent également des facteurs de croissance, des lipides, des cytokines et du miRNA, ce qui leur permet d’agir de manière beaucoup plus large et plus puissante.
👉 Les peptides sont donc précieux, mais les exosomes vont encore plus loin. Ils déclenchent un processus plus complet de réparation et de renouvellement de la peau.
Pourquoi les exosomes sont essentiels pour le rajeunissement de la peau?
Avec l’âge, la production naturelle d’exosomes dans notre corps diminue fortement. Résultat : la communication entre les cellules ralentit, la réparation de la peau devient plus lente, la production de collagène diminue et la peau montre plus rapidement des signes de vieillissement.
En apportant des exosomes de l’extérieur, on redonne à la peau les signaux dont elle a besoin. Cela peut conduire à:
- Une réparation plus rapide de la peau endommagée;
- Une amélioration de la production de collagène et d’élastine;
- Une peau plus ferme, plus élastique et plus lumineuse;
- Une meilleure protection contre les radicaux libres et les agressions extérieures.
Les exosomes sont donc le chaînon manquant dans l’amélioration de la peau et l’anti-âge.
Stabilité: pourquoi la formulation fait la différence
Une question légitime se pose : les exosomes sont-ils réellement stables dans un sérum? Il existe beaucoup de discussions à ce sujet sur le marché, et la réponse fait une grande différence en termes d’efficacité.
Pourquoi souvent poudre + liquide?
Les exosomes sont extrêmement sensibles à la lumière, à la chaleur et surtout à l’oxydation. Sous forme sèche (poudre / lyophilisat), ils sont beaucoup plus stables et les composants actifs restent intacts plus longtemps. Ils ne sont mélangés avec un liquide (activateur) que juste avant l’utilisation. Cela évite qu’ils se dégradent dans le flacon après la production et perdent leur efficacité.
Les exosomes sont-ils stables dans des sérums liquides prêts à l’emploi?
Certaines marques prétendent utiliser des technologies stabilisées, par exemple grâce à l’encapsulation. Mais dans la plupart des cas, les sérums liquides sont beaucoup moins fiables : sans données de laboratoire ou cliniques solides, il est difficile de savoir combien d’exosomes actifs restent après le transport et le stockage.
👉 C’est pourquoi Infuzion Exozome utilise la technologie freeze-dry:
- Exosomes sous forme de poudre, stables et actifs ;
- Activation avec le liquide juste avant l’utilisation ;
- Puissance maximale garantie pendant le traitement.
En résumé : cette différence de formulation rend Infuzion plus fiable et plus efficace que les produits dans lesquels les exosomes restent déjà plusieurs semaines ou mois dans un liquide.
Pourquoi combiner avec le Infuzion System?
Le Infuzion System® est la seule technique capable de remplir jusqu’à 80 % des cellules avec des ingrédients actifs. Grâce à un courant galvanique innovant, des micro-canaux s’ouvrent dans la peau, permettant aux exosomes de pénétrer profondément et uniformément – sans aiguilles, sans douleur et sans temps de récupération.
Contrairement à des techniques comme le microneedling, qui provoquent des micro-lésions, les exosomes restent avec Infuzion totalement intacts et actifs. Cela rend le traitement adapté même aux peaux les plus sensibles.
Question: pourquoi ne pas utiliser les exosomes seuls?
Infuzion Exozomes est l’un des quatre sérums exclusifs du Infuzion System®. La particularité de ce système est qu’il ouvre des micro-canaux dans la peau grâce au courant galvanique. Cela permet aux ingrédients actifs de remplir jusqu’à 80% des cellules.
Sans aiguilles ni douleur
Sans dommages ni temps de récupération
Les exosomes restent intacts et actifs
Sûr même pour les peaux les plus sensibles
Contrairement à des techniques comme le microneedling, qui provoquent des micro-lésions, le Infuzion System® fonctionne entièrement sans aiguilles et sans douleur.
Végétal, sûr et puissant
Infuzion Exozome est 100% d’origine végétale et enrichi en Lithospermum et Shikonin, issus de la racine d’une plante médicinale. Ces ingrédients apportent:
- Une action anti-inflammatoire et antibactérienne;
- Une réduction des rougeurs et des irritations;
- Un soutien pour l’acné, l’eczéma, les éruptions cutanées et la cicatrisation;
- Une protection antioxydante supplémentaire contre le vieillissement de la peau.
Et tout cela sans injections ni traumatisme, de manière totalement sûre et confortable.
Résultats et protocole de traitement
Que peuvent attendre les clients?
Un teint plus lumineux et plus uniforme;
Une amélioration de l’hydratation et de l’élasticité;
Moins de rougeurs et d’inflammations;
Une stimulation naturelle du collagène et de l’élastine.
✅ Après 2 à 3 séances, espacées de 3 à 4 semaines, des résultats visibles apparaissent déjà. L’entretien est ensuite nécessaire seulement tous les 3 à 6 mois.
Questions fréquentes
1. Les exosomes ne sont-ils pas simplement une tendance?
Doute: "Il y a tellement de tendances dans la beauté, comment savoir si ce n’est pas simplement un effet de mode?"
Réponse : Les exosomes sont étudiés scientifiquement dans le monde entier et utilisés dans des contextes médicaux et esthétiques. Il s’agit donc d’une technologie prouvée, et non d’un simple mot marketing.
2. Les exosomes sont-ils sûrs pour mes clients?
Doute: "Puis-je utiliser ce traitement sur tous les types de peau, même les peaux sensibles ou à problèmes?"
Réponse : Les exosomes contenus dans Infuzion Exozome sont d’origine végétale, sans aiguilles et non traumatiques. Grâce à leurs propriétés anti-inflammatoires et apaisantes (Lithospermum et Shikonin), ils conviennent même aux peaux sensibles ou problématiques.
3. Qu’est-ce qui différencie Infuzion des autres marques utilisant des exosomes?
Doute: "De nombreux sérums revendiquent une “technologie exosome”, pourquoi choisir Infuzion?"
Réponse : La différence réside dans la stabilité et la pénétration. Infuzion utilise une technologie poudre freeze-dry + liquide (garantissant des exosomes actifs) combinée au Infuzion System, qui permet jusqu’à 80 % d’absorption dans les cellules. Cette combinaison rend le traitement unique et beaucoup plus efficace.
4. En combien de temps les clients voient-ils des résultats?
Doute: "Les clients attendent des résultats rapides, puis-je le promettre?"
Réponse : Après 2 à 3 séances, des résultats visibles apparaissent (peau plus lisse, teint plus uniforme, peau plus ferme). Ensuite, un entretien est nécessaire seulement tous les 3 à 6 mois, ce qui favorise la satisfaction et les traitements réguliers.
5. Peut-on combiner ce traitement avec d’autres soins?
Doute: "Je propose déjà du microneedling, des peelings ou des soins classiques. Est-ce compatible?"
Réponse : Oui, Infuzion Exozome peut être combiné avec d’autres traitements ou faire partie d’un programme de soins premium. Il renforce les résultats des méthodes existantes.
6. Comment puis-je me différencier en tant qu’institut?
Doute: "Beaucoup d’instituts proposent déjà des soins anti-âge. Pourquoi un client choisirait-il mon institut?"
Réponse : Infuzion Exozomes est exclusivement disponible dans les salons Infuzion. Vous proposez donc un traitement que les clients ne peuvent pas trouver ailleurs, avec des résultats visibles. Cela vous donne un avantage concurrentiel clair.
7. Vais-je recevoir un bon accompagnement?
Doute: "Si je commence avec Infuzion, vais-je être laissé seul?"
Réponse : Infuzion propose des formations, du matériel marketing et un accompagnement continu, afin que vous puissiez démarrer de manière professionnelle et en toute confiance.
Conclusion
Les exosomes ne sont pas une tendance passagère, mais une véritable avancée dans l’amélioration de la peau et l’anti-âge. Là où de nombreux sérums reposent surtout sur le marketing, Infuzion Exozome garantit de vrais résultats grâce à des exosomes actifs et stables, combinés à des actifs végétaux puissants.
C’est le choix idéal pour les instituts qui souhaitent offrir à leurs clients des traitements innovants, efficaces et rentables.
👉 Découvrez la puissance de Infuzion Exozome et contactez-nous dès aujourd’hui pour plus d’informations, de conseils ou une démonstration.